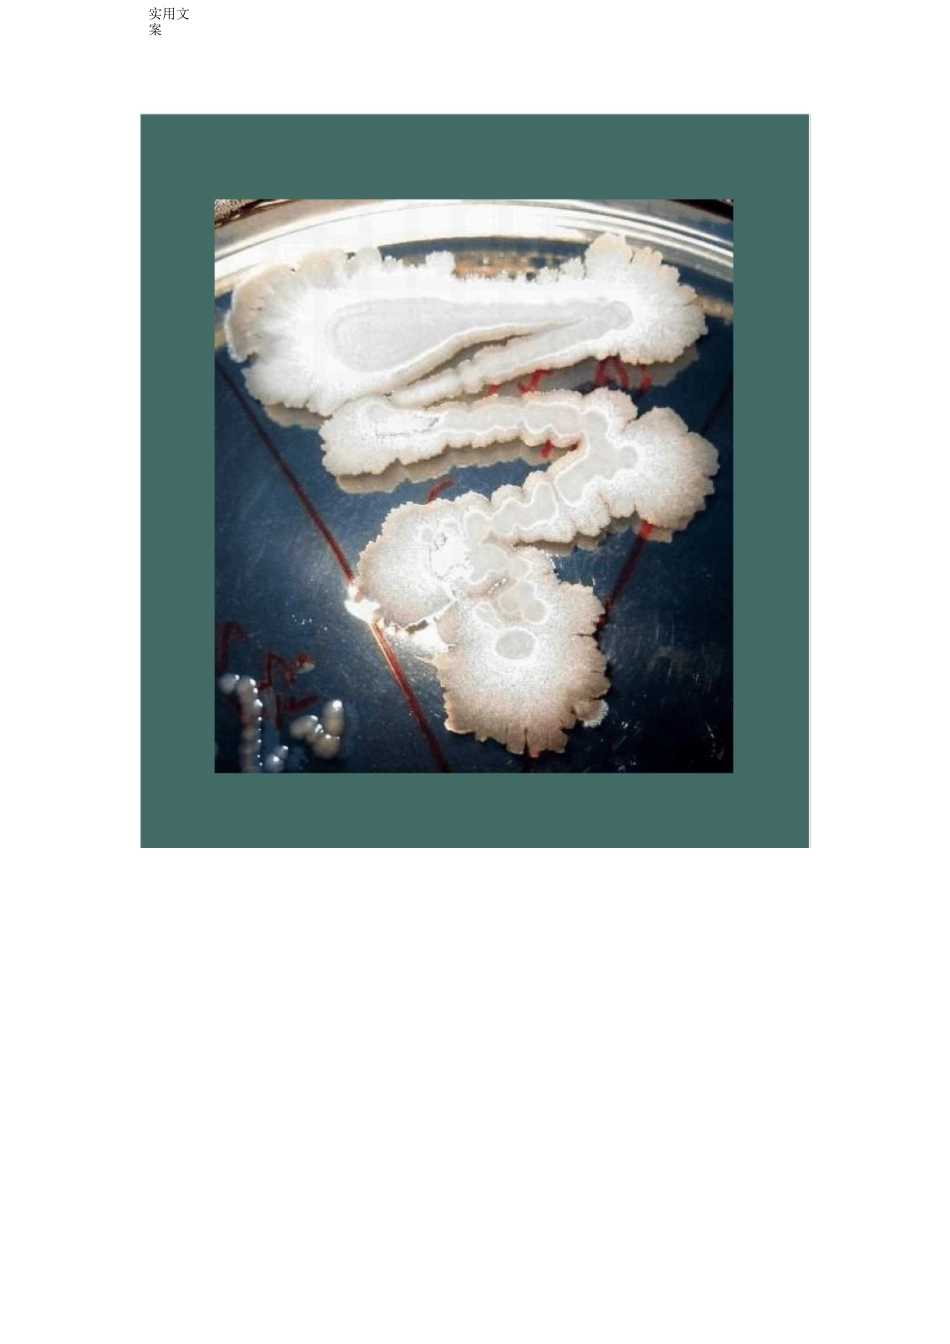
芽孢杆菌形态特征_第1页

蕈状芽胞杆菌:实用文案蕈状芽胞杆菌——营养琼脂 48h 菌落:蕈状芽胞杆菌——革兰氏染色:2•地衣芽胞杆菌:地衣芽抱杆菌:革兰氏阳性杆状
无荚膜,不成链,能运动
芽抱椭圆形至柱状,中生或次端生,0
菌落粗糙,不透明,粘着,扩展
明胶液化,淀粉水解,V
P 试验阳性,柠檬酸盐利用
广泛分布在土壤和食品中
也是实验室中普遍存在的污染菌
从某些菌株培养物中可获得杆菌肽素和地衣形杆菌素
有的能产生碱性蛋白酶
但也是引起罐头食品腐败的平酸腐败菌,是罐头生产中应严加注意的一种污染菌
地衣芽胞杆菌 18h 革兰氏染色:实用文案实用文案实用文案实用文案腊样芽胞杆菌卵磷脂酶:附:卵磷脂酶试验操作:1•鸡蛋一枚浸泡于 75%酒精中 30min〜24h;2
50 或 100ml 小三角烧瓶,放置 10 粒左右玻璃珠,盛 10ml 生理盐水,15P 灭菌 15min;3
根据用量配制营养琼脂,15P 灭菌 15min(与盐水同时高压;4•用无菌小镊子在已灭菌的鸡蛋两端打孔,让蛋清流出,弃之不用;5•打开蛋壳使蛋黄全部留入三角瓶中,轻轻摇匀,玻璃珠起搅匀蛋黄的作用;6•琼脂温度至 45 度左右,以 10%量加入蛋黄液(无菌吸管),摇匀,倒平板(4mm 规格平即可,太大浪费);7•将待检菌点种(穿刺)入平板,35 孵育,菌落周围有如图所示混浊圈即为卵磷脂酶阳性•否则,阴性
试验结果如下图:实用文案蜡样芽抱杆菌:杆状,1
末端方,成短或长链
革兰氏阳性,无荚膜,运动
芽抱椭圆形,中生或次端生,1
5 微米,抱囊无明显膨大
菌落大,表面粗糙,扁平,不规则
它可用于明胶液化,牛奶胨化,还原硝酸盐,水解淀粉
广泛分布于土壤、灰尘、牛奶以及植物外表
另外还有其变种一蕈状芽抱杆菌,也是土壤中常见细